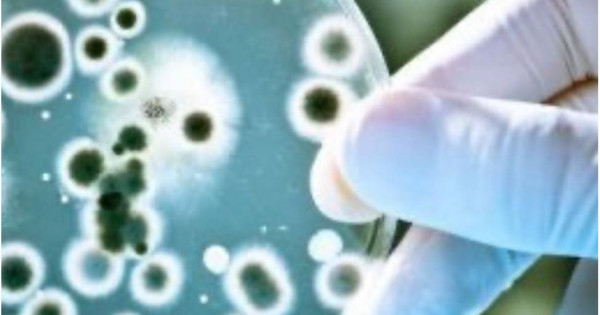

Foto: DenMinPR
Densaýlyq saqtaý mınıstrliginiń baspasóz qyzmetiniń málim etýinshe jyl basynan beri barlyǵy 17 jaǵdaı tirkelgen.
Sibir jarasy – bul aýyl sharýashylyǵy janýarlaryna jáne jabaıy ańdarǵa, sondaı-aq adamdarǵa áser etetin asa qaýipti ınfeksııalyq aýrý. Aýrý kóbinese aýyr aǵymmen ótedi jáne ólimge ákelýi múmkin. Sibir jarasynyń qozdyrǵyshy – topyraqta jyldar boıy saqtalatyn sibir jarasy mıkroby. Infeksııa aýrý janýarlarmen, olardyń etimen jáne mal ónimderimen, sondaı-aq topyraq arqyly baılanys bolǵan kezde týyndaıdy.
«Aýrýdyń ınkýbasııalyq kezeńi birneshe saǵattan 14 kúnge deıin, biraq kóbinese sımptomdar ınfeksııadan keıin 3-6 kúnnen keıin paıda bolady. Olarǵa jalpy álsizdik, joǵary temperatýra, lımfa túıinderiniń isinýi jáne júrek soǵýynyń joǵarylaýy jatady. Adam sibir jarasy aýrýyna shaldyqqan janýarlardan juqtyrýy múmkin. Olarǵa iri qara, jylqy, esek, qoı, eshki, buǵy, túıe jatady», dep túsindirdi vedomstvo.
Infeksııa janýarlarǵa kútim jasaý, soıý, et óńdeý kezinde, sondaı-aq mal sharýashylyǵy ónimderimen – teri, meh buıymdary, jún, qylshyqtarmen jumys istegen kezde juǵýy múmkin. Bundaı jaǵdaıda sporalar jyldar boıy, sonyń ishinde topyraqta da saqtalady. Jermen baılanys arqyly sporalar teridegi mıkrojaraqattarǵa túsedi. Bul sibir jarasynyń teri túriniń damýyna ákeledi. Bul – naýqastardyń arasynda eń kóp taralǵan túri.
Sibir jarasynyń aldyn alý úshin tómende kórsetilgendi eskerý qajet:
- jeke gıgıena sharalaryn saqtaý;
- janýarlardy vaksınasııalaý;
- aýrý (ólgen) janýarlardy óz betinshe soımaý;
- belgisiz jerlerde saýda jasaıtyn adamdardan et satyp almaý;
- satýshydan «veterınarlyq qorytyndy» talap etý.
Et kombınattarynyń qyzmetkerlerine, veterınarııalyq qyzmetkerlerge, sibir jarasynyń qozdyrǵyshymen jumys isteıtin zerthanalardyń qyzmetkerlerine vaksınamen profılaktıkalyq egýler alý qajet.





































